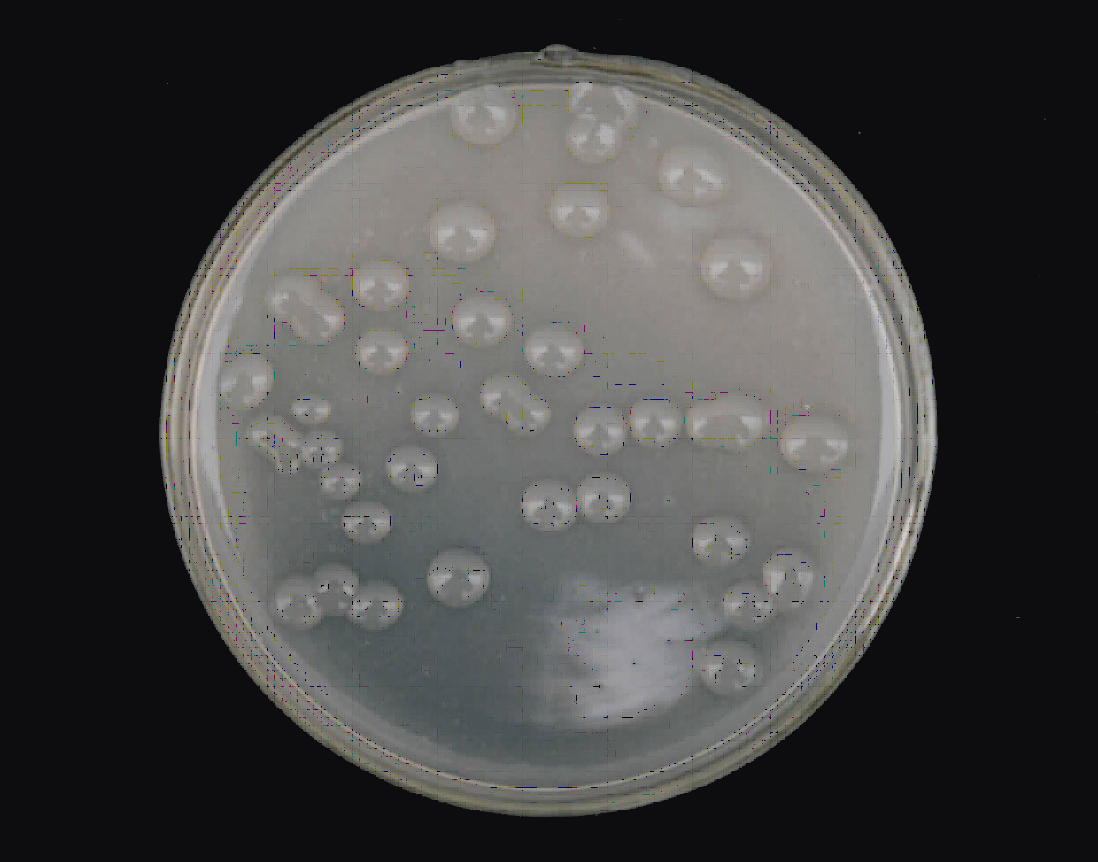

産品名稱:三糖鐵(tiě)瓊脂培養基
廠家(jiā):瑞楚生(shēng)物
貨号:T1111
規格:250g/瓶
微生(shēng)物在地球上(shàng)廣泛存在,發揮着重要的生(shēng)态和(hé)生(shēng)物化學功能。為(wèi)了深入了解微生(shēng)物的生(shēng)态特性、代謝途徑以及其在環境中的作(zuò)用,科研人(rén)員需要開(kāi)發出有(yǒu)效的培養基來(lái)支持微生(shēng)物的生(shēng)長和(hé)繁殖。在這方面,三糖鐵(tiě)瓊脂培養基作(zuò)為(wèi)一種特殊的培養基,在微生(shēng)物學研究中具有(yǒu)重要作(zuò)用。本文将介紹三糖鐵(tiě)瓊脂培養基的組成、特點以及其在科研中的應用。
三糖鐵(tiě)瓊脂培養基的組成與制(zhì)備:
三糖鐵(tiě)瓊脂培養基是一種含有(yǒu)三種糖類(葡萄糖、乳糖和(hé)蔗糖)和(hé)鐵(tiě)鹽的瓊脂培養基。其基本組成包括:
1.碳源: 葡萄糖、乳糖和(hé)蔗糖作(zuò)為(wèi)微生(shēng)物的碳源,提供能量和(hé)碳元素供微生(shēng)物生(shēng)長代謝所需。
2.氮源: 通(tōng)常含有(yǒu)氨基酸、蛋白胨等氮源,供微生(shēng)物合成蛋白質等生(shēng)物分子所需的氮元素。
3.微量元素與維生(shēng)素: 三糖鐵(tiě)瓊脂培養基中含有(yǒu)鐵(tiě)鹽,其作(zuò)為(wèi)微量元素,對于一些(xiē)鐵(tiě)依賴性微生(shēng)物的生(shēng)長是必要的。同時(shí),維生(shēng)素等輔助因子也會(huì)被添加,以滿足微生(shēng)物在培養基中的生(shēng)長需求。
4.瓊脂: 作(zuò)為(wèi)固化劑,使培養基成為(wèi)固體(tǐ)狀态,提供微生(shēng)物生(shēng)長的支撐結構。
特點與應用:
1. 選擇性: 三糖鐵(tiě)瓊脂培養基常常用于分離和(hé)鑒定大(dà)腸杆菌等腸道(dào)細菌。其中的三種糖類在細菌代謝中會(huì)産生(shēng)不同的代謝産物,從而區(qū)分不同種類的細菌。此外,鐵(tiě)作(zuò)為(wèi)微量元素的添加,也可(kě)以使得(de)對鐵(tiě)依賴性微生(shēng)物的生(shēng)長得(de)到促進,從而實現選擇性生(shēng)長。
2. 檢測葡萄糖發酵能力: 葡萄糖在三糖鐵(tiě)瓊脂培養基中的存在,使得(de)可(kě)以通(tōng)過微生(shēng)物是否能夠發酵葡萄糖來(lái)檢測其代謝能力。發酵産物會(huì)改變培養基顔色,從而可(kě)以初步判斷微生(shēng)物的代謝類型。
3. 微生(shēng)物鑒定: 通(tōng)過觀察培養基上(shàng)微生(shēng)物的生(shēng)長情況、顔色變化等特點,可(kě)以初步判斷微生(shēng)物的種類。結合其他鑒定方法,如生(shēng)化測試、分子生(shēng)物學技(jì)術(shù)等,可(kě)以更準确地鑒定微生(shēng)物。
4. 環境微生(shēng)物學研究: 三糖鐵(tiě)瓊脂培養基在環境微生(shēng)物學研究中有(yǒu)着廣泛的應用。通(tōng)過分離和(hé)培養環境樣品中的微生(shēng)物,可(kě)以了解不同環境中微生(shēng)物的多(duō)樣性、分布情況以及其代謝特性,從而揭示微生(shēng)物在生(shēng)态系統中的作(zuò)用。
結論:
三糖鐵(tiě)瓊脂培養基作(zuò)為(wèi)一種特殊的培養基,在微生(shēng)物學研究中發揮着重要作(zuò)用。其獨特的組成以及在微生(shēng)物代謝和(hé)鑒定中的應用,使得(de)科研人(rén)員能夠更好地理(lǐ)解微生(shēng)物的特性與功能。然而,需要注意的是,三糖鐵(tiě)瓊脂培養基雖然在一些(xiē)微生(shēng)物的分離與鑒定中表現優異,但(dàn)并不适用于所有(yǒu)微生(shēng)物,因此在選擇培養基時(shí)應根據具體(tǐ)的研究目的和(hé)微生(shēng)物特性進行(xíng)合理(lǐ)選擇。随着微生(shēng)物學技(jì)術(shù)的不斷發展,三糖鐵(tiě)瓊脂培養基必将在更廣泛的領域中展現其重要價值。